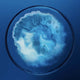
Biotherm Homme Force Supreme Gel rewitalizujący żel do twarzy 50ml

Biotherm Homme Force Supreme Gel rewitalizujący żel do twarzy 50ml
Najniższa cena z ostatnich 30 dni: 206,21 zł
Ostatnie sztuki Darmowa dostawa od 399 zł
Szczegóły
Szczegóły
| Nazwa produktu: | Homme Force Supreme Gel rewitalizujący żel do twarzy 50ml |
|---|---|
| Marka: | Biotherm |
| Pojemność: | 50ml |
Ten ultraodświeżający, rewitalizujący żel przeciwstarzeniowy został stworzony z myślą o mężczyznach, którzy chcą widocznie poprawić kondycję skóry i zredukować oznaki starzenia. Jego lekka, szybko wchłaniająca się formuła natychmiast dodaje skórze energii, wygładza jej powierzchnię i pomaga zmniejszyć widoczność zmarszczek oraz kurzych łapek. Dzięki połączeniu ekstraktów z niebiesko-zielonych alg o właściwościach wzmacniających oraz restrukturyzującego Pro-xylane™ skóra odzyskuje jędrność, elastyczność i młodszy wygląd. Regularne stosowanie sprawia, że cera jest bardziej napięta, promienna i widocznie odnowiona.
Rezultaty:
Po aplikacji skóra staje się gładsza, bardziej promienna i ożywiona, a drobne linie są mniej widoczne. Potwierdzone pomiarami efekty*: +23% większa sprężystość skóry, +14% większa jędrność. Po 4 tygodniach**, 90% mężczyzn zauważa poprawę jędrności skóry, 83% deklaruje mniejszą widoczność zmarszczek, 90% dostrzega większą elastyczność, a 93% ocenia swoją skórę jako zregenerowaną.
*Test instrumentalny, 30 osób, po 4 tygodniach
**Samoocena, 40 osób
Główne składniki:
Formuła została wzbogacona o niebiesko-zielone algi, które wspierają restrukturyzację skóry i przywracają jej młodzieńczy wygląd. Pro-xylane™ poprawia elastyczność, ujędrnia skórę i wzmacnia jej strukturę.
Konsystencja:
Ultrafresh, lekka żelowa konsystencja, która błyskawicznie się wchłania, nie pozostawiając tłustego filmu.
Stosowanie:
Nakładaj żel na oczyszczoną skórę rano i/lub wieczorem. Możesz stosować samodzielnie lub jako pierwszy krok pod krem.
Dane producenta
Dane producenta
Ostrzeżenia
Ostrzeżenia
Czas i koszt dostawy
Czas i koszt dostawy
InPost Paczkomat 24/7 Przewidywany czas dostawy: 1 dzień roboczy
13,89 złInPost Kurier Przewidywany czas dostawy: 1 dzień roboczy
13,99 zł
Automaty DHL BOX 24/7 | Punkty POP Przewidywany czas dostawy: 1 dzień roboczy
12,99 złDHL Kurier Przewidywany czas dostawy: 1 dzień roboczy
13,99 złORLEN Paczka Przewidywany czas dostawy: 1 dzień roboczy
9,99 złPocztex PUNKT/AUTOMAT Przewidywany czas dostawy: 1 dzień roboczy
7,49 złKurier Pocztex Przewidywany czas dostawy: 1 dzień roboczy
9,90 złKurier za pobraniem
+3,00 zł